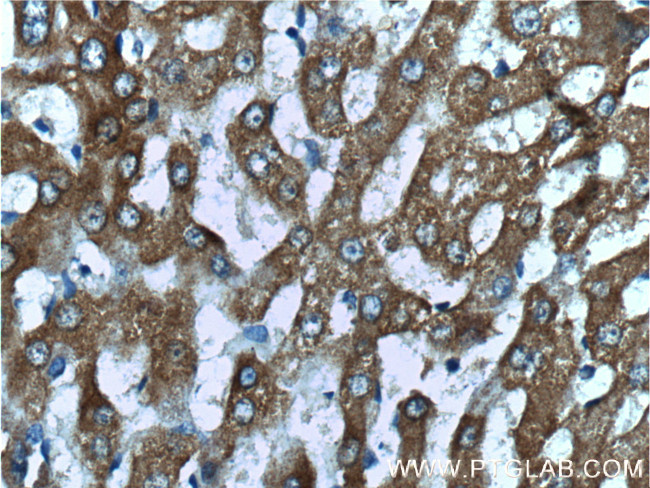
GRHPR Antibody in Immunohistochemistry (Paraffin) (IHC (P))

Search
Proteintech
GRHPR Polyclonal Antibody
{{$productOrderCtrl.translations['antibody.pdp.commerceCard.promotion.promotions']}}
{{$productOrderCtrl.translations['antibody.pdp.commerceCard.promotion.viewpromo']}}
{{$productOrderCtrl.translations['antibody.pdp.commerceCard.promotion.promocode']}}: {{promo.promoCode}} {{promo.promoTitle}} {{promo.promoDescription}}. {{$productOrderCtrl.translations['antibody.pdp.commerceCard.promotion.learnmore']}}
产品信息
51013-2-AP
种属反应
宿主/亚型
分类
类型
抗原
偶联物
形式
浓度
规格
纯化类型
保存液
内含物
保存条件
运输条件
产品详细信息
Immunogen sequence: VGYTPDVLT DTTAELAVSL LLTTCRRLPE AIEEVKNGGW TSWKPLWLCG YGLTQSTVGI IGLGRIGQAI ARRLKPFGVQ RFLYTGRQPR PEEAAEFQAE FVSTPELAAQ SDFIVVACSL TPATEGLCNK DFFQKMKETA VFINISRGDV VNQDDLYQAL ASGKIAAAGL DVTSPEPLPT NHPLLTLKNC VILPHIGSAT HRTRNTMSLL AANNLLAGLR GEPMPSELKL (100-328 aa encoded by BC000605)
靶标信息
This gene encodes an enzyme with hydroxypyruvate reductase, glyoxylate reductase, and D-glycerate dehydrogenase enzymatic activities. The enzyme has widespread tissue expression and has a role in metabolism. Type II hyperoxaluria is caused by mutations in this gene.
仅用于科研。不用于诊断过程。未经明确授权不得转售。
篇参考文献 (0)
生物信息学
蛋白别名: 2-HAD; epididymis secretory sperm binding protein; glycerate-2-dehydrogenase; glyoxylate reducatase; D-glycerate dehydrogenase; glyoxylate reductase and hydroxypyruvate reductase; Glyoxylate reductase/hydroxypyruvate reductase; unnamed protein product
基因别名: 1110059D05Rik; 6430629L09Rik; GLXR; GLYD; GRHPR; MSTP035; PH2
UniProt ID: (Human) Q9UBQ7, (Mouse) Q91Z53
Entrez Gene ID: (Human) 9380, (Mouse) 76238